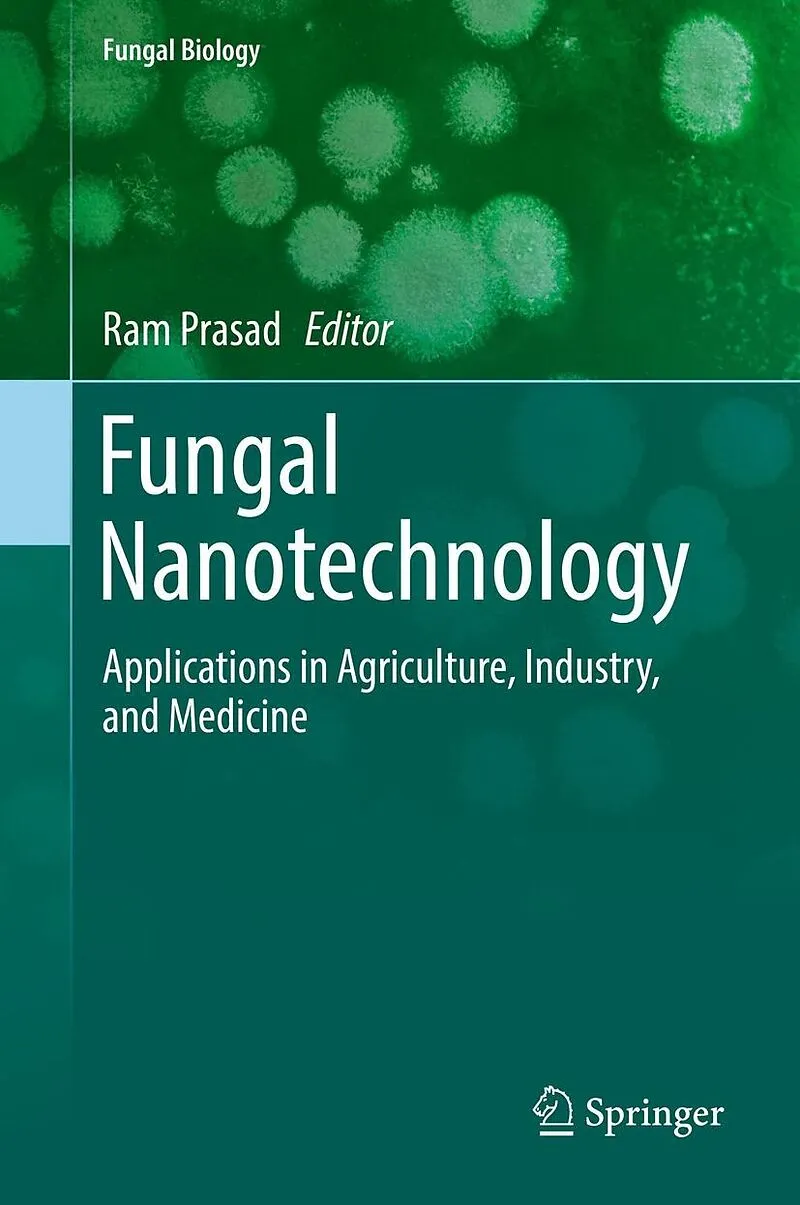

Beschreibung
Presents the potential of fungal nanotechnology in developing new products Includes its wide-range of applications to biomedicine, agriculture, and the environment Features contributions from scientists across the globe Autorentext Ram Prasad is Assistant Pro...